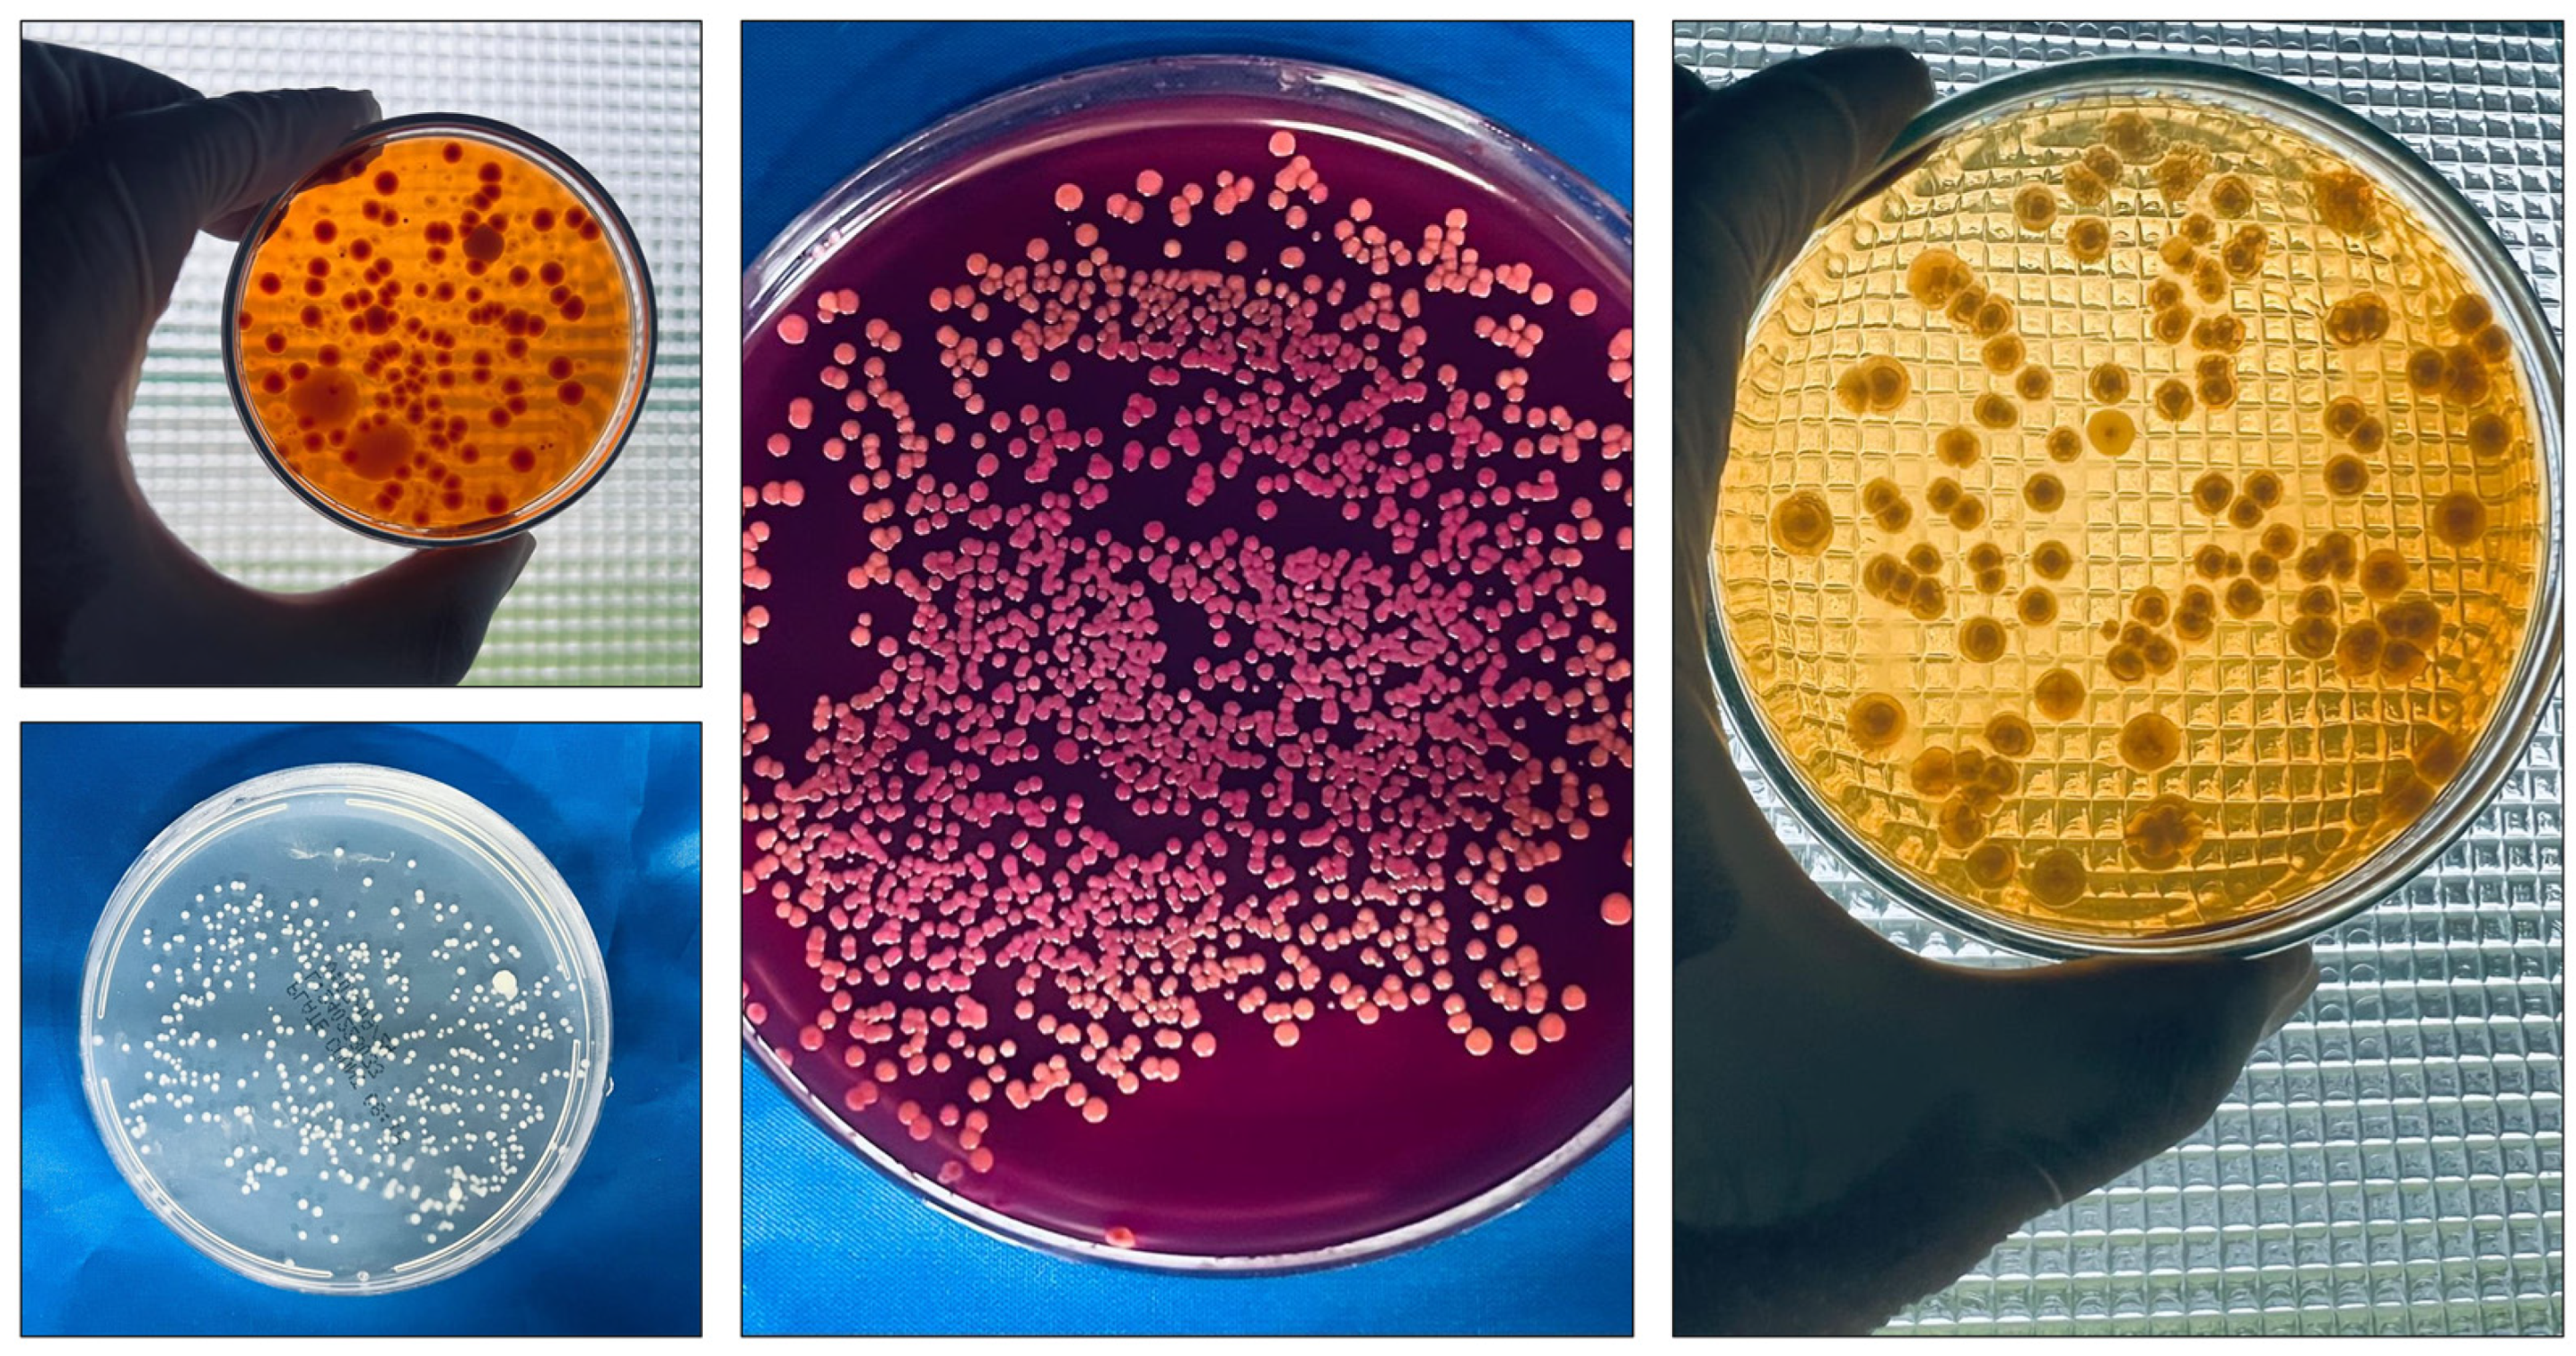
Antibiotics 13 01066 g001

1. Introduction
Embryonic development is a complex physiological process characterized by intricate communication between the internal and external structures of eggs. This sophisticated dialog between structures is essential for the proper development of the embryo. However, the interactions between the eggshell and the embryo present a significant duality. Although these interactions can promote embryonic development, they can also be harmful. The eggshell, as it is an interface with the external environment, is subject to the presence of various contaminants, including pathogenic microorganisms [
1,
2]. Microbiological tests confirmed the presence of microbial contamination on the eggshell post collection (
Figure 1). This contamination can compromise the integrity of the embryo, negatively impacting its development [
3]. Sanitary practices are needed to mitigate the risk of bacterial contamination in hatcheries, feed and input storage areas, and facilities supporting poultry activities, such as administrative areas, bathrooms, changing rooms, laboratories, and warehouses. The same attention should be given to production facilities, sanitization rooms, egg storage areas, egg transport vehicles, and personal hygiene practices, with particular emphasis on sanitizing hatching eggs.
Sanitizers used in poultry farming are normally formulated with a synthetic chemical base (e.g., formaldehyde, glutaraldehyde, or quaternary ammonium) and have been proven to be efficient at reducing the level of contamination by pathogenic bacteria that cause fatal infections [
4,
5,
6,
7]. On the other hand, these sanitizers can also be associated with health problems ranging from allergic skin reactions to the development of malignant cancer [
8,
9,
10,
11]. This problem worsens when companies do not warn users of their sanitizers that they must handle these with personal protective equipment. Poultry researchers, teachers, and professionals play vital roles in the theoretical and practical education of poultry producers and managers about advanced sanitization techniques, adherence to healthy sanitizers, modification of harmful protocols, and immediate recognition of complications and irregularities in practice.
The selection of hatching egg sanitizers that contain compounds derived from plants, such as essential oils, can be a beneficial decision, considering the results of reviews, published in renowned scientific journals, on the benefits of essential oils for the sanitization of hatching eggs and the protection of human health [
12,
13,
14,
15,
16,
17,
18]. Oliveira et al. [
12] suggested the use of essential oils as sanitizing agents for hatching eggs, emphasizing their safety and effectiveness in reducing the microbial load on eggshells, which can significantly increase hatchability rates. Lesgards et al. [
18] favored the advancement of essential oils in medical research, highlighting that these compounds may exhibit advanced anticancer properties by inducing cell death in cancer cells without affecting normal cells.
The plants
Citrus aurantifolia (Tahiti lemon),
Ocimum basilicum (basil), and
Allium sativum (garlic) (
Figure 2) are among the best-known sources of essential oils worldwide.
Citrus aurantifolia is a plant that can reach an average height of 5.10 m and a canopy area of approximately 17.50 m
2, with an estimated volume of 105.16 m
3. The leaf area can reach 16.53 cm
2. Each tree can produce an average of 405 fruits, with a fruit set rate of 30.95%, yielding approximately 18.64 kg/tree. The number of flowers/clusters can reach 7.00, and the number of fruits/clusters can reach 2.17. The fruits can have a juice content of approximately 39.89%, with total soluble solids measuring 7.64 °Brix. The acidity can reach 7.94%. Each fruit may contain an average of 24.49 mg of ascorbic acid/100 mL of juice. The polar diameter of the fruits is 3.31 cm, the equatorial diameter is 3.17 cm, and the average volume is 42.36 mL. The average peel thickness can reach 2.33 mm [
19].
Ocimum basilicum is a plant that can reach an average height of 53.4 cm, with approximately 16.0 branches/plant. The plant diameter can reach approximately 41.0 cm. The leaf blade has an average length of 6.4 cm and a width of 3.4 cm. The time to flowering can reach 72 days, with approximately 32.2 inflorescences per plant, each averaging 15.6 cm in length, and approximately 11.1 clusters/main stem. In terms of the yield, the average plant weight can reach 153.4 g. The yield of fresh herbs can reach 16.6 kg/100 m
2, whereas the yield of air-dried herbs can reach 3.5 kg/100 m
2. The plant can also contain an essential oil content of 1.03% and has an essential oil efficiency of 0.31 g per plant [
20].
Allium sativum can reach an average height of 67.40 cm and produces approximately 7.80 leaves per plant, with an average leaf length of 34.20 cm and a leaf width of 3.01 cm. The bulb can have a neck thickness of 1.45 cm and a diameter of 3.70 cm. The bulb yield per plant can average 25.33 g, with approximately 20.55 cloves per bulb. Each clove weighed an average of 2.62 g, with a length of 1.01 cm and a diameter of 1.04 cm. The total soluble solids can reach approximately 36.01% [
21].
The essential oil extracted from the
Citrus aurantifolia (CAEO) plant is an aromatic natural compound that is predominantly composed of hydrocarbons in the form of monoterpenes and sesquiterpenes, with D-limonene as the main component [
22]. This essential oil was effective in inhibiting in vitro bacterial strains, such as
Escherichia coli,
Pseudomonas aeruginosa,
Staphylococcus aureus, and
Bacillus subtilis, in addition to the fungus
Candida albicans [
22]. The essential oil extracted from
Ocimum basilicum (OBEO) is a light yellowish and volatile substance, which composition is dominated by monoterpenes, sesquiterpenes, and phenylpropanoids, with estragole as the main constituent [
23]. Exhibiting potent antimicrobial activity in vitro, this oil is effective against methicillin-resistant
Staphylococcus aureus,
Staphylococcus aureus,
Staphylococcus epidermidis,
Enterococcus faecalis,
Bacillus subtilis,
Bacillus cereus,
Escherichia coli,
Pseudomonas aeruginosa,
Acinetobacter baumannii,
Salmonella spp.,
Klebsiella pneumoniae, and
Candida albicans [
23]. The essential oil extracted from
Allium sativum (ASEO) is a bioapplicable natural chemical solution that stores several bioactive compounds. This essential oil has demonstrated significant in vitro antibacterial activities against several bacterial strains, including
Escherichia coli,
Pseudomonas aeruginosa,
Staphylococcus aureus, and
Listeria innocua [
24]. Remarkable findings were obtained from in vivo tests, where CAEO, OBEO, and ASEO showed robust abilities to substantially decrease the bacterial loads on the shells of hatching eggs [
14]. This reduction was particularly evident with mesophilic and enterobacteria [
14].
The antimicrobial properties of CAEO, OBEO, and ASEO are not inferior to those of commercial sanitizers [
14]. This not only promotes a substantial reduction in microbial contamination but also can encourage the production of next-generation antimicrobials based on CAEO, OBEO, and ASEO, with the capacity to promote green poultry farming [
25]. As we continue to explore and better understand these essential oils within the poultry industry, new findings have emerged to strengthen the development of advanced natural antimicrobial solutions capable of meeting the needs of the poultry industry, which is increasingly aware of the importance of sustainability. Therefore, this study aimed to provide a thorough evaluation of the effects of CAEO, OBEO, and ASEO on hatching eggs. This assessment ranges from evaluating the microbiology of eggshells after the application of these oils to analyzing newly hatched chicks. This study seeks to fill gaps in the understanding of the potential benefits of these essential oils in the face of the microbial challenges faced by poultry farms in the management of hatching eggs.
2. Results and Discussion
The main options for controlling the bacterial contamination of eggshells on commercial poultry farms are based on conventional therapies, such as fumigation with formaldehyde (FA) [
6]. However, this sanitization model can lead to adverse effects, as both poultry and humans cannot tolerate constant exposure, especially at high concentrations, because of potential health risks [
26,
27,
28,
29]. Sanitizing eggshells is essential for bacterial control, but the sanitizers used in this process raise significant concerns regarding health and safety. In our previous study [
14], we reported that CAEO, OBEO, and ASEO effectively reduce the bacterial loads on eggshells. In this study, we expand this investigation and demonstrate how approaches based on CAEO, OBEO, and ASEO can influence the hatching and health parameters of poultry.
We began our study with a series of analyses to characterize the hatching eggs. This step was crucial to ensure that the eggs were suitable for subsequent evaluations and to minimize potential biases that could affect the study’s primary objective. The qualities and microbiological characteristics of the eggs are detailed in
Table 1. After confirming that the eggs met the expected normal parameters, we proceeded with the subsequent stages of the study.
To elucidate the antibacterial effects of the essential oils on the eggshells, we counted mesophilic bacteria and Enterobacteriaceae at three distinct time points: once before incubation and twice during the incubation process. Overall, we found that compared with the other treatments, the essential oils were notably more effective (
p < 0.05) at reducing eggshell contamination (
Table 2). In addition to significantly lowering the initial bacterial counts, the essential oils demonstrated superior control of contamination recurrence, keeping the bacterial loads stable until the 18th day of incubation. The contamination levels observed on eggshells sanitized with the essential oils during incubation were lower than that in the reference treatment (FA), with the essential oils showing significantly reduced loads of mesophilic bacteria and Enterobacteriaceae on the 18th day of incubation. Until the ninth day of incubation, the eggshells treated with CAEO and ASEO were free of Enterobacteriaceae. On the ninth day, the Enterobacteriaceae loads were minimal on eggs sanitized with OBEO but did not significantly differ from those in the groups treated with the other essential oils. On the other hand, eggshells sanitized with FA, the standard model from the supplier farm, were less effective at preventing recontamination, as they presented significant increases in mesophilic bacteria and Enterobacteriaceae loads during incubation. The ASEO was the most effective at reducing the bacterial contamination of the eggshells.
More specifically, the essential oils reduced, on average, 70.53% of the mesophilic bacterial loads, and no Enterobacteriaceae were detected during the pre-incubation period. On the ninth day, the average reductions were 66.21% for mesophiles and 92.97% for Enterobacteriaceae. On the 18th day, the reductions were 62.89% for mesophiles and 73.54% for Enterobacteriaceae. These data are consistent with the findings presented in our previous review [
12], where we demonstrated that on the basis of various studies, essential oils can reduce the number of mesophilic bacteria by up to 80.77%. These results are also supported by previous analyses of hatching egg sanitizers based on
Lavandula angustifolia [
30],
Origanum vulgare [
31], and
Cuminum cyminum [
32]. The reasons why essential oils kill bacteria are well documented. The main reasons for this include the inhibition of biofilm formation; the induction of apoptosis mediated by oxidative stress; the disruption of DNA synthesis; the leakage of intracellular proteins, ATP, and nucleic acids; and changes in the metabolic profile, which encompasses amino acid restriction and disturbances in energy metabolism [
33,
34].
On the basis of the ultrastructural analysis of the eggshells after sanitization, we observed that non-sanitized eggshells maintained remarkably preserved structural integrity, with few visible flaws and a consistently smooth surface texture (
Figure 3). The cracks observed on the eggshell surface were minimal, small in extent, and scattered, with no significant interconnectivity. The surface appeared uniform, with a smooth texture and few irregularities or aggregates. There were almost no visible particles or contaminants, suggesting a clean and intact surface with minimal signs of wear. On the other hand, eggshells sanitized with essential oils exhibited cracks ranging from few and superficial to numerous and deep, with from minimal to significant interconnectivity. The surface homogeneity also varied, ranging from good uniformity to a marked lack of uniformity. The presence of particles on the eggshell surface varied from a few to a substantial number. The wear on the shells ranged from mild to severe. Specifically, eggshells sanitized with OBEO showed no signs of advanced degradation, whereas those treated with CAEO and ASEO presented considerable stress and surface deterioration. We suggest that a significant portion of the effects observed on eggs sanitized with essential oils was associated with the GA used as a solvent. Eggshells sanitized solely with GA presented deep, interconnected cracks covering a large part of the surface, characterized by poor homogeneity, a highly irregular texture, and a marked presence of defects. The significant number of particles indicated degradation and contamination, with clear signs of structural failure on the surface. Eggshells sanitized with FA showed significant patterns of cracks that increased in complexity as the magnification of the analysis increased. The cracks were deep, interconnected, and present throughout the surface. This surface was the least homogeneous among all the treated surfaces, with an extremely irregular texture and signs of failure in multiple areas. The presence of particles was widespread and intense, indicating a high likelihood of contamination and/or internal degradation. The wear of the eggshells in this treatment group was extreme, with severe degradation, and the structure appeared to be on the brink of complete failure. Therefore, as expected, the non-sanitized eggshells presented the best scenario in terms of the integrity, whereas the eggshells sanitized with FA were the most compromised, severely affecting the structural integrity.
Overall, the incubation process was concluded at 516 h and 12 min, but the first hatch occurred at 469 h and 49 min, whereas the last hatch occurred at 501 h and 27 min, covering a period of 31 h and 38 min. This hatch window is within the expected range for commercial setters [
35]. Previously, an incubation cycle involving non-sanitized eggs and those sanitized with ethyl alcohol, essential oils, or FA lasted an average of 31 h and 45 min [
36].
We quantified the eggs’ weight loss based on the eggs’ initial weights and observed that the eggs sanitized with the essential oils did not show weight losses different from those of the non-sanitized eggs (
Table 3). In contrast, the eggs sanitized with FA showed weight losses that exceeded the ideal limit required to ensure an adequate air cell by the end of embryonic development [
37]. Losses of this magnitude have a significant impact on embryonic development; for example, excessive internal water loss can cause severe dehydration in the embryo [
37]. The elevated weight losses of the eggs sanitized with FA corroborate the observation that it was the sanitizing agent that most compromised the integrity of the eggshell (
Figure 3). In contrast, the damage caused by the essential oils to the eggshells did not result in weight losses outside the normal range observed for eggs treated with these oils (
Figure 3). One possible explanation for this phenomenon is that despite the combination of alcohol and oil causing damage to the shells, the oily and residual characteristics of the essential oils, even at low concentrations, may have minimized the significant weight loss. Importantly, in recent years, essential oils have been used in egg coatings to improve their structures and reduce weight loss in eggs stored for more than 20 days [
38,
39,
40].
To gain insights into hatching outcomes, we analyzed the hatchability rate of fertile eggs in response to the sanitizers applied to the eggshells (
Table 3). First, we observed that under the same incubation conditions, the conventional FA-based sanitizer significantly reduced (
p < 0.05) the hatchability rate, whereas the essential oils promoted the highest hatchability rates. Our hatchability results are in close alignment with previous findings on the sanitization of eggs using essential oils of
Syzygium aromaticum at a concentration of 0.39% [
41] and
Cuminum cyminum and
Origanum vulgare, each at 0.5% [
32]. Compared with non-sanitized eggs, the application of these essential oils led to significant increases in hatch rates: for every 320 incubated eggs, 34 additional eggs successfully hatched. Similarly, for
C. cyminum and
O. vulgare, for every 50 incubated eggs, 6 more eggs hatched than in the untreated control group. Oliveira et al. [
13] conducted a review that contrasted the effects on hatchability of eggs sanitized with FA and essential oils. The review revealed that on average, essential oils do not produce inferior results compared with FA in terms of hatchability.
Embryonic mortality can be divided into three phases (
Figure 4). We compared the mortality rates among the treatments. FA increased (
p < 0.05) the rate of early embryonic mortality compared with both non-sanitized eggs and those treated with GA and essential oils (
Table 3). Considering the average rate of early mortality associated with essential oils, we demonstrated that compared with FA, these oils reduced the mortality rate during this period by approximately 75%. The high early mortality rate observed in eggs sanitized with FA can possibly be attributed to the residual presence of this compound on the eggshell during the first days of development or because it can fix itself to the internal contents of the eggs. Similarly, Bekhet [
42] reported an increase in the early embryonic mortality rate for eggs sanitized with FA. No differences were found for intermediate or late mortality rates among the treatments. The highest number of contaminated embryos was expected for the non-sanitized eggs, as these eggs are exposed to a more significant bacterial challenge than are the sanitized eggs.
To the best of our knowledge, our study is pioneering in linking the sanitization of hatching eggs with essential oils and the level of bacterial contamination in the yolk sac. Our findings indicate that interventions with CAEO, OBEO, and ASEO reduced (
p < 0.05) the mesophilic bacterial load by 55.36% and the Enterobacteriaceae load by 56.98% in the yolk sacs of 18-day-old embryos (
Table 4). Our hypothesis is that the use of essential oils helps to maintain low bacterial levels on the eggshell, thereby impeding the penetration of contaminating bacteria into the embryo. In this way, the embryo benefits from the antibacterial barrier created by the essential oils on the eggshell. Li et al. [
43] corroborated our findings. They did not isolate nalidixic-acid-resistant
E. coli in any of the yolk sac samples from chicks hatched from eggs artificially contaminated with bacteria on the shell and subsequently sanitized with 1.5% lysozyme. In contrast, when sanitization was performed with distilled water instead of lysozyme, 40% of the yolk sac samples contained
E. coli. Although partial, our recent findings also provide important support for our previous hypothesis that the sanitization of hatching eggs with essential oils contributes to significant reductions in the microbial loads of newly hatched chicks [
44]. We also noticed that a significant number of dead embryos due to contamination were identified in the non-sanitized eggs, whereas no mortality was recorded among embryos from the eggs sanitized with OBEO or ASEO (
Table 3). Thus, we demonstrated the relationships among the practice of sanitizing eggshells, the reduction in bacterial counts on the eggshells, and the survival rates and bacterial qualities of the embryos. FA did not have the potential to reduce the bacterial loads in the yolk sacs of the embryos.
Although the essential oils did not influence the chick weights, FA significantly reduced (
p < 0.05) the chick weight compared with those of chicks from the non-sanitized eggs. This reduction is probably because of the degree of embryo dehydration caused by excessive egg weight loss during incubation because of eggshell damage. According to Aviagen [
45], the low weights of chicks compared with what is expected on the basis of the weight of the eggs, indicating poor yield, is associated with chick dehydration, reduced yolk reserves, and excessive levels of activity and noise. Compared with the non-sanitized eggs, the hatching eggs sanitized with the essential oils tended to produce healthier chicks, with a significant difference observed only for OBEO (
Table 5). To identify the main cause of the decline in chick quality from the non-sanitized eggs, we conducted a detailed analysis of individual factors (reflex, navel, legs, and beak). The analysis revealed that poor navel healing was the primary factor responsible for the reduced quality of the chicks hatched from the non-sanitized eggs (
Figure 5). These findings highlight the importance for sanitizing hatching eggs. Among the treatments, OBEO produced the healthiest chicks.
FA caused morphological changes, ranging from mild to moderate, in the tracheae and lungs of the embryos in all the embryo samples (
Table 6;
Figure 6 and
Figure 7). Our findings corroborate the results of histological analyses carried out by Turkish researchers, who, approximately 16 years ago, confirmed that sanitizing hatching eggs with FA has adverse effects on the embryos’ tracheae [
46]. Given the ability of FA to penetrate eggshells after exposure [
27], especially owing to the damage caused to the shells’ integrity, we suggest that there may be an accumulation of toxic chemical compounds within the eggs’ internal compartments, with implications that extend throughout embryonic development. Although we previously suggested that proper sanitization of hatching eggs with FA could prevent adverse effects on embryonic development [
44], our recent results highlight the need for further investigation to understand the factors that favor the toxic effects of FA on embryos, even when applied under appropriate conditions. To advance this field, we propose a multifactorial study on the sanitization of hatching eggs with FA that considers the characteristics of eggshells from different genetic strains; the purity, formulation, and quality of the FA; and the genetic variation of the embryos.
Unlike those treated with FA, trachea and lung samples from embryos in the essential oil group presented no detectable morphological changes (
Table 6,
Figure 7 and
Figure 8). These findings suggest that the potential penetration and accumulation of essential oils in the embryonic environment do not reach levels capable of inducing morphological alterations in the poultry respiratory system. Oliveira et al. [
13] also demonstrated that chicks hatched from eggs sanitized with
Syzygium aromaticum essential oil did not exhibit histopathological changes in the trachea. This allows us to speculate that although poultry have tissues with varying degrees of sensitivity, the embryonic mortalities observed in the group exposed to the essential oils were not attributable to toxicity associated with the egg sanitization process using these natural compounds. This conclusion is supported by previous studies that reported the absence of histopathological alterations in the digestive, cardiovascular, and central nervous systems and muscular tissues of one-day-old chicks hatched from eggs sanitized with essential oils [
13,
32].
Changes in the chorioallantoic membrane (CAM) became visible after the application of the sanitizing solutions (
Figure 9). GA caused lysis in the CAMs of all eight embryos tested within the first 30 s post application, as exemplified in
Figure 9. To determine whether the severe toxicity observed when the essential oils were diluted in GA was, indeed, attributable to the solvent, we evaluated the membranes exposed to the pure essential oils. We found that although the pure essential oils were highly concentrated compared with the tested dilutions, they exhibited low toxicities. None of the eight CAMs evaluated showed lysis, hemorrhage, or coagulation within the first 2 min of exposure, which contrasts with the results observed in the other treatments. We provide a robust scientific foundation for the topical use of essential-oil-based sanitizers on eggshells, reaffirming that this management approach is safe and, in cases of embryonic contact, minimal and non-toxic. Exposure to GA, which is used as a diluent, did not significantly affect the embryonic viability; if excessive or prolonged penetration occurred, we would have observed elevated embryo mortality associated with massive hemorrhages, coagulation, and lysis of blood vessels. These findings underscore that sanitizing with essential oils diluted in GA is a safe practice. However, under no circumstances should GA be used as a diluent for injectable applications because of its potential risk of embryonic damage. For injecting essential oils into eggs, we strongly recommend using alternative and proven safe diluents. For example, the medium-chain triglycerides used as a diluent for essential oils in hen’s egg test chorioallantoic membrane (HET-CAM) assays did not induce irritation to the CAM, as evidenced by the absence of hemorrhage, coagulation, and vasoconstriction [
47].
3. Materials and Methods
The CAEO (extracted from the fruit peel by pressing) (Phytoterápica
®, Rio de Janeiro, Brazil), OBEO (extracted from the leaves and flowers by steam distillation) (BioEssência
®, São Paulo, Brazil), and ASEO (extracted from the rhizomes by steam distillation) (Laszlo
®, Minas Gerais, Brazil) were purchased commercially. The chemical composition of each essential oil was identified via gas chromatography coupled with mass spectrometry. The three main compounds in the CAEO were D-limonene (18.32%), p-cymene (18.04%), and limonene 1,2-diol (7.10%). In OBEO, the main constituents were estragole (69.57%), linalool (20.70%), and (E)-α-bisabolene (2.22%) (BioEssência
®, São Paulo, Brazil). In the ASEO, the highlights were di-2-propenyl-trisulfide (30.72%), diallyl disulfide (18.95%), and methyl and allyl trisulfide (11.84%) [
48].
For this antibacterial assay [
49],
S. aureus and
E.
coli (100 μL; optical density: 0.5 McFarland; American Type Culture Collection, Manassas, VA, USA) were inoculated separately on Mueller–Hinton agar (Difco, BD, Sparks, MD, USA). Sterile disks (6 mm in diameter; Laborclin, Pinhais, Paraná, Brazil) were supplemented with 10 μL of CAEO, OBEO, or ASEO. These disks, including the antibiotic (azithromycin at 15 μg; Laborclin, Pinhais, Paraná, Brazil) and sterilized distilled water disks, were transferred to the surface of the already inoculated Mueller–Hinton agar (Difco, BD, Sparks, MD, USA) and incubated at 36 °C for 24 h. Inhibition zones were measured to confirm the antibacterial activities. A procedure similar to that described above was also used to evaluate the minimum inhibitory concentrations (MICs) of the essential oils. In a Petri dish containing 100 µL of the bacterial suspension seeded on Muller–Hinton agar (Difco, BD, Sparks MD, USA), sterile disks soaked with 10 µL of CAEO, OBEO, or ASEO diluted in 0.5% Tween 80 at twenty concentrations ranging from 300 to 0.0003 mg/mL were fixed. Tween 80, at a concentration of 0.5%, served as a negative control, and azithromycin at 15 μg (Laborclin, Pinhais, Paraná, Brazil) served as a positive control. The plates were incubated for 24 h at 36 °C.
The three lowest effective concentrations of each essential oil, determined via the disk diffusion method, were tested in triplicate via the broth dilution method to confirm the effectiveness of these concentrations [
50]. In this test, each essential oil was diluted until it reached the three desired concentrations in test tubes containing Mueller–Hinton broth (Difco, BD, Sparks, MD, USA), followed by the addition of the bacterial strains. In one of the tubes, the essential oil was not diluted, serving as a negative control. After the tubes were incubated at 36 °C for 24 h, the efficiency of each oil was visually measured in the absence of bacterial growth. The MIC value was recorded as the lowest concentration of each essential oil that inhibited bacterial growth.
The essential oils inhibited both bacteria (
Figure 10), depending on the concentration tested. CAEO demonstrated inhibitory activity against
E. coli at concentrations ranging from 300 to 9.38 mg/mL, with inhibition zones between 28.33 and 9.33 mm. Similarly, it was effective against
S. aureus at concentrations ranging from 300 to 1.17 mg/mL, with inhibition zones ranging from 30.33 to 7.67 mm. OBEO demonstrated antimicrobial activity against
E. coli at concentrations ranging from 300 to 1.17 mg/mL, with inhibition zones ranging from 16.67 to 7.00 mm. For
S. aureus, the concentrations ranged from 300 to 4.69 mg/mL, with inhibition zones between 12.67 and 7.67 mm. ASEO oil exhibited a potent inhibitory effect on
E. coli at concentrations ranging from 300 to 0.29 mg/mL, with inhibition halos ranging from 36.33 to 7.67 mm. The inhibition of
S. aureus occurred at concentrations ranging from 300 to 1.17 mg/mL, with halos ranging from 32.00 to 8.00 mm. As a reference, the positive control showed average inhibition zones of 23.67 mm for
E. coli and 22.00 mm for
S. aureus. Although higher concentrations may be more effective at reducing eggshell contamination [
51], they can also result in increased operating costs, potential damage to the integrity of the shell’s cuticular layer [
52], and the blockage of pores [
53] and a consequent reduction in the hatchability rate [
12,
53]. The lowest concentration of each essential oil tested, which demonstrated effectiveness in the disk diffusion method, also proved to be effective in the broth dilution method. Therefore, to prepare each essential-oil-based sanitizer, the lowest concentration of each oil that was effective against both bacteria was selected.
A flock of 58,138 breeder hens from a commercial farm located in Planaltina, the Federal District, Brazil, was subjected to rigorous and comprehensive testing. The results confirmed that the flock was completely free of
Salmonella spp.,
Mycoplasma gallisepticum, and
Mycoplasma synoviae, ensuring the high quality and safety of the collected eggs. This conclusion is based on extensive bacteriological and serological analyses of samples, including serum, egg, meconium, and cloacal swabs. These tests provide a reliable foundation for the subsequent experimental procedures [
54,
55].
A total of 1695 hatching eggs from broiler breeders (flock 27) aged 57 weeks, from the Pescoço Pelado Vermelho (PSÇ) lineage, were donated by this commercial farm. The accumulation of fecal matter and feed residue on the surface of hatching eggs can inactivate the antimicrobial properties of sanitizers or impair the interactions between them and microorganisms [
27,
56,
57,
58]. When collecting, the professionals at the donor farm discarded all the eggs that were cracked, broken, and/or had excess organic matter. Therefore, all the donated eggs were clean and intact and were subjected to sanitization using GA, FA, CAEO, OBEO, or ASEO. A control group was not subjected to any sanitization with the mentioned products. A total of 275 hatching eggs were used and appropriately identified for each treatment.
Before sanitization, the internal quality of the hatching eggs was initially tracked to assess the viability of the embryonic microenvironment and ensure that these eggs were as healthy as possible. For this analysis, 30 eggs were identified, weighed, and then carefully opened using scissors. The contents were gently dispersed on a glass surface. Initially, the height of the albumen was measured using a digital caliper. The yolk was subsequently separated from the albumen with a yolk separator, and its diameter and height were measured with a digital caliper. To complete the analysis, the pH values of the albumen and yolk of all the eggs were measured using a calibrated pH meter. The final results were obtained by applying the collected data to the formulae for the Haugh unit (HU = 100 log (albumen height + 7.57 − 1.7 egg weight
0.37) [
59] and the yolk index (YI = yolk height/yolk diameter) [
60].
The eggs intended for the microbiological analysis were immediately placed in sterile bags (Labplas, Sainte-Julie, QC, Canada) after collection and stored under refrigeration (approximately 5 °C) until the analysis, which was carried out 24 h later. The microbiological quality characteristics of the contents of 15 hatching eggs were evaluated using a method similar to that described by Figueiredo et al. [
61], with some modifications. For the analysis, 15 mL of the egg content was collected. These samples were placed in labeled sterile plastic bags (Labplas, Sainte-Julie, QC, Canada) to which 135 mL of 0.1% peptone water (Laborclin, Pinhais, Paraná, Brazil) was added. The plastic bags containing the solutions were then homogenized for two minutes. Serial dilutions of the homogenized solutions were carried out in 0.1% peptone water (Laborclin, Pinhais, Paraná, Brazil). The bacterial load was then quantified by plating 100 μL of the dilutions on plate count agar and red violet bile glucose agar (Ionlab, Araucária, Paraná, Brazil). These culture media were selected for counting the total aerobic mesophilic bacteria and Enterobacteriaceae, respectively. The plates were incubated at 36 °C for a period of 48 h. After this interval, the numbers of developed colonies were recorded and expressed as decimal logarithms (log
10).
To prepare the sanitizers, each essential oil was carefully diluted in GA until it reached the following final concentrations: CAEO, 9.38 mg/mL; OBEO, 4.69 mg/mL; and ASEO, 1.17 mg/mL. The concentration of the GA used as a vehicle for the essential oils, was 93.8%. FA, at a concentration of 5 g/m
3, was applied to the eggs through fumigation in a closed environment for 15 min, following the routine standards established at the farm. The liquid sanitizing solutions were applied to the eggs (~2.5–3 mL/egg) via hand sprayers. The eggs were left to dry naturally at room temperature for approximately 30 min. The non-sanitized eggs were kept under similar conditions. From preparing the solutions to their application, the professionals involved were properly equipped with masks, gloves, protective glasses, lab coats, and caps. According to Franco et al. [
62], eggs must be sanitized within 30 min after collection, as delays in cleaning can favor a reduction in chicken viability because of contamination. All the eggs were sanitized simultaneously 20 min after collection and then sent to an experimental laboratory for artificial incubation.
We evaluated the bacterial counts on the eggshells, following a methodology similar to that used in this study for analyzing the microbiological content of the eggs, with adaptations from the protocol described by Shahein and Sedeek [
36] (
Figure 11). We subjected hatching eggs (nine eggs/treatment) to washing for two minutes in 0.1% peptone saline solution (Laborclin, Pinhais, Paraná, Brazil) and placed them in sterile transparent bags (Labplas, Sainte-Julie, QC, Canada). Each bag was filled with 165 mL of the solution along with three eggs/treatment. Serial dilutions of the washing solutions were carried out in 0.1% peptone water (Laborclin, Pinhais, Paraná, Brazil). We conducted this analysis in triplicate per treatment immediately after sanitization on the ninth and 18th days of incubation.
We prepared eight eggshells from each treatment for scanning electron microscopy (SEM) analysis following the protocol established by Mahato et al. [
63]. After the internal contents were removed, the eggshells were carefully washed with distilled water. The eggshell membrane was then removed using tweezers. A small equatorial section of the shell, approximately 5 mm × 5 mm in size, was subsequently extracted and boiled in a 2% sodium hydroxide solution for 10 min to remove any residual membrane. The samples were rinsed again with distilled water and left to air-dry at room temperature for 12 h. The dried samples were then metalized and examined under a JEOL JSM-7001F scanning electron microscope (Jeol Ltd., Akishima, Tokyo, Japan) at standard magnifications of ×100, ×500, ×1000, and ×3000.
Before the hatching eggs arrived at the experimental laboratory, the egg storage chamber and setters were rigorously cleaned and sanitized. The storage chamber and setters were initially washed with water and detergent. Then, the sanitizer Lysoform (2.5%; SC Johnson, Racine, WI, USA) was applied and left to act for at least 10 min, according to the manufacturer’s recommendation. The eggs were stored for 24 h in a storage chamber with a controlled temperature between 19 and 21 °C and a relative humidity between 50 and 60%. After the storage period, the incubation and hatching methodology adopted by Oliveira et al. [
64] was used. Briefly, the eggs were weighed after storage and incubated in single-stage setters (Chocmaster, Curitiba, Paraná, Brazil), as illustrated in
Figure 12. A total of four setters were used. In each incubation tray, the eggs from each treatment group were distributed randomly. During incubation, the mean temperature was maintained at 37.7 °C, and the mean relative humidity was 60%. Egg turning occurred automatically every hour, as recommended by Oliveira et al. [
65]. Candling was performed individually on each egg on the 10th day of incubation, allowing for the removal of infertile eggs and those with embryonic mortality. During the birth period, the mean temperature was adjusted to 36.6 °C, and the mean relative humidity was adjusted to 65%. The climatic variables of the incubation room were monitored every five minutes via a HOBO data logger (Onset, Bourne, MA, USA) during the 21 days of incubation, ensuring the optimal functioning of the setters.
The parameters used to evaluate the feasibility of the egg sanitization during incubation and hatching were as follows: egg weight loss (%), hatchability of fertile eggs (%), early dead (%), mid dead (%), late dead (%), and contaminated eggs (%), according to the methodology described by Baylan et al. [
66], with very few changes. To evaluate the quality of the hatched chicks, we used the Pasgar score, which considers the reflexes, navel, legs, and beak, according to the methodology described by Boerjan [
67]. Next, the bodyweights of the same chicks were measured using a high-precision analytical scale (Gehaka, São Paulo, São Paulo, Brazil).
In accordance with the methodology of Upadhyaya et al. [
68], the bacterial load of the yolk sac contents was determined. Seven chick embryos from each treatment were removed from the setter at 18 days of development and euthanized by cervical dislocation by a trained researcher, with the aim of collecting the contents of the yolk sac. To ensure the sterility and integrity of the procedure, the bags containing the yolk sac contents were transferred to sterile transparent bags (Labplas, Sainte-Julie, QC, Canada), each containing 150 mL of 0.1% peptone saline solution (Laborclin, Pinhais, Paraná, Brazil). The contents were then homogenized for two minutes. The homogenized solutions were subjected to serial dilutions following a careful and standardized protocol. This procedure employed the same microbiological counting methods as those used previously (
Figure 11).
In this investigation, six embryos from each treatment group at 18 days of development were euthanized by cervical dislocation to assess the effects of the sanitizing solutions on the poultry respiratory system. In line with ethical and methodological standards, necropsies were conducted, and tissue samples from the tracheae and lungs were collected. These samples were fixed in 10% buffered formalin (pH 7.0), embedded in paraffin, and stained with hematoxylin and eosin (H&E). A semi-quantitative analysis of the pathological changes in all the tissues was performed, and the results were categorized as absent (−), mild (+), moderate (++), or severe (+++). Epithelial cell degeneration/necrosis, goblet cell hyperplasia, and lymphocytic inflammation were the main lesions evaluated in the tracheae (adapted from Hayretdağ and Kolankaya [
46]). Bronchial epithelial degeneration/necrosis and congestion were histologically assessed in the lungs.
We measured the toxicity profiles of the sanitizing solutions on embryos via HET-CAM [
69]. A total of 120 non-sanitized hatching eggs (mean weight: 56.33 ± 3.64 g) from 51-week-old PSÇ-lineage broiler breeders (batch 21) were incubated until the 9th day of embryonic development, under the same conditions described in the “incubation and hatching” section, in a single-stage setter (Premium Ecologica, Belo Horizonte, Minas Gerais, Brazil). After this period, all the eggs were subjected to candling to confirm embryonic development. In embryonated eggs, an opening was made in the shell above the air chamber with the help of surgical scissors. After being moistened with a 0.9% saline solution, the eggshell membranes were carefully removed to expose the CAMs. Then, 200 μL of each sanitizing solution, at the same concentration used to sanitize the eggshells, was pipetted onto the membrane. Each sanitizing solution was applied to eight eggs, except for the treatments with the essential oils, which were applied to 16 eggs: eight with GA as the carrier and eight without GA as the carrier. The harmful effects of the sanitizing solutions were evaluated based on the degrees of hemorrhage, coagulation, and lysis of the blood vessels of the CAMs, as described in detail in the study by Derouiche and Abdennour [
70]. Observations, after the sanitizing solutions were applied, were carried out with the aid of a magnifying glass, allowing for detailed monitoring of their effects on the CAMs.
We conducted the experiment in accordance with a completely randomized design, which included six treatments and four repetitions in each treatment group, with 60 eggs per repetition. We performed the bacterial counts of the eggshells in triplicate, and the bacterial analysis of the yolk sac was conducted in seven repetitions, with each embryo considered as an independent experimental unit. Analysis of variance was performed via PROC GLM. Tukey’s test was used to compare the treatment means (p < 0.05). We used SAS Studio University Edition software (SAS Inst. Inc., Cary, NC, USA) for all the statistical analyses.